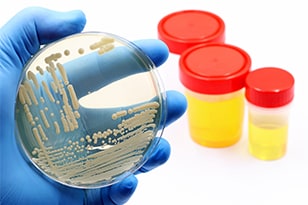
Culture of yeast Candida auris Image of microbiological culture of yeast Candida auris, responsible for urinary tract infections (UTIs)

Search
Search

Urinary tract infections (UTIs) are considered among the most prevalent diseases globally, affecting approximately 400 million people and resulting in 240,000 deaths each year.1
While most UTIs are considered uncomplicated and common, there is another type of UTI that can be more serious. A complicated UTI has a higher risk of treatment failure and recurrence. Severe cases can lead to urosepsis and can be fatal. Identifying the causative agent and determining susceptibility are paramount to treating these cases.
Although widely used, culture-based urine testing methods for the detection of urinary tract pathogens are cumbersome. They require up to 30 hours of culturing time, lack sensitivity, are subjective, and have been shown to miss a significant percentage of positive cases.
Real-time PCR (qPCR), especially when paired with standard culture methods, has shown clinical evidence for molecular detection of UTI pathogens to support effective patient outcomes.
Real-time PCR (qPCR), especially when paired with standard culture methods, has clinical evidence for molecular detection of UTI pathogens to support effective patient outcomes3. PCR can be performed to target a single pathogen, or multiplex PCR can simultaneously detect multiple targets and organisms in a single reaction. Such simultaneous detection of various pathogens could aid clinical decision-making, allowing quicker and more specific treatments, which may lead to fewer recurrent infections resulting from inadequate or inappropriate treatments4. PCR can also be performed in the context of large syndromic panels that can be designed to identify a wide range of possible targets. Such panels are molecular tests that detect more than one pathogen associated with similar and overlapping clinical symptomatology5.
Urine culture is performed in a clinical microbiology laboratory and is used for assessing growth and concentration, and identifying the causative pathogen. Standard urine culture testing takes multiple days to process and yields a substantial number of false-negative results (30-50%) because of colonization and lack of sensitivity6.
Polymerase chain reaction (PCR), or molecular testing, offers highly sensitive and specific detection and quantification of molecular biomarkers. Multiplexing capabilities, fast turnaround times, and simple workflows have made PCR a popular diagnostics choice for many clinical applications7.
Urine dipsticks that detect nitrates, leukocyte esterase, blood, proteins, pH, and/or glucose are fast (1-2 hours) but lack accuracy and sensitivity and cannot be used to provide a microbiological diagnosis.
Microscopy can be used to quantify leukocytes and differentiate between gram-negative and gram-positive bacteria, but sample handling, storage, and staining techniques limit the utility of microscopy alone.
Bacteria | |
|---|---|
Acinetobacter baumanni | Klebsiella pneumoniae |
Citrobacter freundii | Morganella morganii |
Enterobacter aerogenes | Proteus mirabilis |
Enterobacter cloacae | Proteus vulgaris |
Enterococcus faecalis | Providencia stuartii |
Enterococcus faecium | Pseudomonas aeruginosa |
Escherichia coli | Staphylococcus saprophyticus |
Klebsiella oxytoca | Streptococcus agalactiae |
Mechanisms of antibiotic resistance in Urinary Tract Infections: Why does Anti-Microbial Resistance Pose a Challenge?
Despite technological innovation, antibiotic resistance (ABR) remains an ongoing and evolving threat. Learn about the mechanisms bacteria use for resistance and how they continue to challenge the infectious disease community.
Get the facts on urinary tract infections. Modes of infection, prevalence, testing options, management, and clinical value of molecular testing.
ASM 2023 On Demand Workshop - Emerging Trends in the Diagnosis and Management of UTIs: Technical and Policy Considerations
Watch this recorded workshop from the 2023 American Society for Microbiology annual meeting titled: Emerging trends in the diagnosis and management of UTIs: technical and policy considerations.
Watch these short videos and explore the considerations for UTI diagnosis and management with Dr. Mohit Mathur, Chief Medical Officer of Pathnostics.
1. Yang X, Chen H, et al. (2022) Disease burden and long-term trends of urinary tract infections: A worldwide report. Front. Public Health 10:888205. doi: 10.3389/fpubh.2022.888205
2. Laudisio A, Marinosci F, et al. The burden of comorbidity is associated with symptomatic polymicrobial urinary tract infection among institutionalized elderly. Aging Clin Exp Res. 2015;27(6):805-812. doi:10.1007/s40520-015-0364-x
3. Ashok, A., Ko, D., et al. (2022). Comparison of guidance UTI® and standard urine culture for rates of sepsis, hospitalization and other adverse outcomes in complicated urinary tract infections. Journal of Urology, 207(Supplement 5), e550. https://doi.org/10.1097/ju.0000000000002583.09
4. Wojno KJ, Baunoch D, et al. Multiplex PCR Based Urinary Tract Infection (UTI) Analysis Compared to Traditional Urine Culture in Identifying Significant Pathogens in Symptomatic Patients. Urology. 2020;136:119-126. doi:10.1016/j.urology.2019.10.018
5. Centers for Medicare & Medicaid Services. (2022). MolDX: Molecular syndromic panels for infectious disease pathogen identification testing. Centers for Medicare & Medicaid Services. https://www.cms.gov/medicare-coverage-database/view/lcd.aspx?lcdid=39001&ver=4
6. Klipp J (2022) Spotlight interview: Pathnostics' CEO Dave Pauluzzi. Laboratory Economics 17(7). https://pathnostics.com/wp-content/uploads/2022/07/Pathnostics.LE_.Reprint.pdf
7. The qPCR Ecosystem and State of qPCR in Molecular Diagnostics https://thermofisher.com/blog/clinical-conversations/the-qpcr-ecosystem-and-state-of-qpcr-in-molecular-diagnostics/